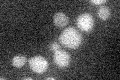
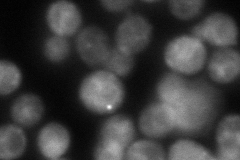
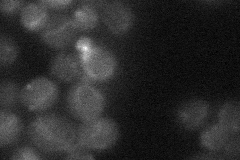
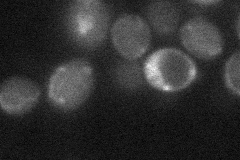
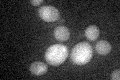

View description
Putative lipoate-protein ligase, required along with Lip2 and Lip5 for lipoylation of Lat1p and Kgd2p; similar to E. coli LplA; null mutant displays reduced frequency of mitochondrial genome loss
Localization:
Intensity:
Fold change:
Significance:
-
C’ GFP library in SD
below threshold18.02 -
N' NOP1pr-GFP in SD

mitochondria104.09 -
N' TEF2pr-mCherry in SD
mitochondria26.8145 -
N' NATIVEpr-GFP in SD
punctate19.4251 -
N' TEF2pr-VC and Cyto-VN in SD
below threshold22.4355 -
C’ GFP library in SD+DTT
cytosol14.870.82No -
C’ GFP library in SD+H2O2

cytosol170.94No -
C’ GFP library in Starvation Media

cytosol14.30.79No -
C’ GFP library on the background of Pup2-DaMP

below threshold -
C’ GFP library on the background of CCT mutant

below threshold17.53630.972843No
